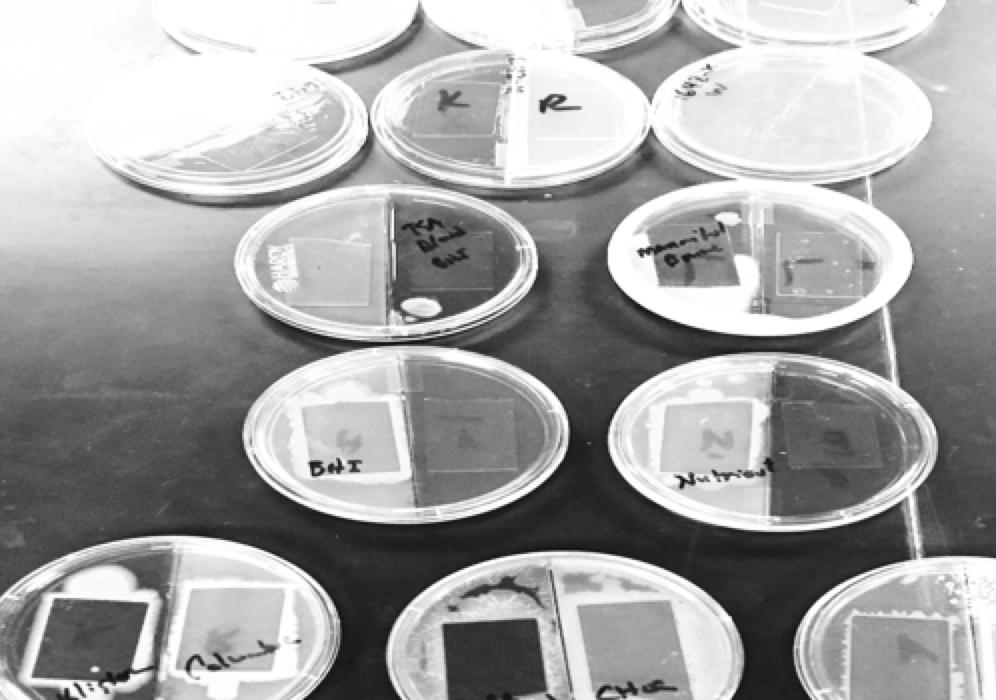

State of Dixie State University





Dixie State University is a public, comprehensive university dedicated to rigorous learning and the enrichment of the professional and personal lives of its students and community by providing opportunities that engage the unique Southern Utah environment and resources.


July 2015: Two bachelor’s degrees in Dance added
August 2015: DSU’s new “active learning. active life.” motto revealed
August 2015: Women’s volleyball wins PacWest Championship
September 2015: Bachelor’s degree in Media Studies added
December 2015: Bachelor’s degree in Exercise Science added
January 2016: Burns Offces addition is completed

March 2016: DSU students help with disaster relief in New Orleans for Alternative Spring Break
April 2016: DSU unveils the Trailblazer athletic identity and Brooks the Bison as mascot
April 2016: Men’s golf wins PacWest championship
June 2016: Zions Bank donates Steinway piano worth $162,000, helping DSU work toward All-Steinway School status
July 2016: Smith’s Computer Center remodel completed
July 2015 :
Bachelor’s degree in Individualized Studies added
August 2015: Groundbreaking for new housing, Campus View Suites, takes place

September 2015: Bachelor’s degree in Communication Studies added
September 2015: DSU’s Strategic Plan kickoff
January 2016: DSU holds second annual MLK Jr. Day Celebration and
March 2016:
DSU & U of U receive annual appropriation of $1.5 million from
April 2016: Legend Solar donates $10 million to DSU’s stadium project

April 2016: DSU partners with UVU to offer international student-
May 2016: DSU & Duy Tan University in Vietnam form international
July 2016:
Bachelor’s degree in Digital Film approved

Trailblazing from status to stature
• Academic Excellence
• Equity and Inclusion
Accountability
• Service leadership
• Local and Global Resources
August 2016: LGBTQ+ Center opens
Overview
Encouraging Excellence, Cultivating Creativity, and Pioneering Pathways Learning, Engagement, Opportunity Creativity and Innovation
Defined Identity


Branding







Branding







Awards:
The Sammy Award Sales & Marketer of the Year – PR Launch Utah Business














Best Viewbook – Paragon Award
Best College Promotional Brand Video – Paragon Award

Best Video Shorts (single or series) Paragon Award












Best Original Photography Manipulated – Paragon Award •The Medallion GOLD Award for the Outdoor Media –
The Medallion GOLD Print Ad Single –
•The Medallion SILVER Award for Notes/Cards/Invitations

















•The Medallion SILVER Award for Original Photography – Manipulated NCMPR
•The Medallion SILVER Award for Sports Brochure or Sports Program NCMPR
•The Medallion SILVER Award for Successful Recruitment or Marketing Program













Single or Series NCMPR
Single or
NCMPR
Series
Singer Series NCMPR
New Learning Motto



active learning. active life.

Academic Vision




our Academic
• Our History • Regional Workforce Development • Regional Economic Development
Designing
Programs
Polytechnic Approach


Technology • Engineering • Business
Applied Sciences
Health Sciences
•
•
•
4,700+
Colleges and Universities in US

32 Institutes of Technology/Polytechnics



15
New Programs

New Degrees:
Bioinformatics
Applied Sociology
Studio Art
Health Administration

Population Health- Public Health
Recreation and Sport Management
Information Systems and Data Analytics

•
•
•
•
•
•
•
U of U Partnership Program






Digital Film Program







Looking Glass









Institute of Politics




Osmond


Dixie Online





 Ryan Hobbs
Ryan Hobbs
Innovation Plaza

Success Academy expansion
Technology, Innovation & Entrepreneurship (TIE) Center






Dixie Innovation Guidance & Solutions Program (DIGS)

•
•
•
Dr. Wayne Provost







Dixie Innovation & Guidance Solutions (DIGS)

35 students, 4 faculty, and 20 community members
8 community members with patent applications
2 student patent applications in the que
3 student patent applications
1 faculty patent application
•
•
•
•
•
CODE SCHOOL
The goal of the DSU STEM K–16 Pipeline is to build and sustain an educational and engaging course for students in Southern Utah to fill the demand for qualified tech talent in the local private sector and fuel the robust labor market. Of the 400 DSU CIT students in 2015, there were 40 graduates. We aim to not only boost the number of students but also increase the number of qualified, job-ready graduates.
K–16 Pipeline
FIRST Lego League: grades K–9
Minecraf: grades K–9
Tech Savvy: girls grades 6–9
eSmart: girls grades 7–8
Code Camp: grades K–adult
CodeChangers: grades 2–12
Computer Camps: grades 2–12
WCSD Concurrent Enrollment: grades 10–12
Girls Go Digital: grades 2–12
SUCCESS Academy: grades 10–12
Code School: 18 years–up
Design School: grades 11–up
Internships: University level
DXATC: grades 10–up
DESIGN SCHOOL DXATC 25
OPEN JOBS IN REGIONAL TECH MARKET
41 800 K–12 STUDENTS FROM 5 SOUTHERN UTAH COUNTIES *
K
SUCCESS ACADEMY COMPUTER CAMPS INTERNSHIPS TECH SAVVY MINECRAFT CODE CHANGERS eSMART CODE CAMP GIRLS
DIGITAL LEGO LEAGUES
indeed.com
GO
WCSD PROGRAMS
*Beaver, Garfield, Iron, Kane, Washington
COLLEGE OF SCIENCE AND TECHNOLOGY 24 bachelor’s degrees 10 minors 2 associate degrees 2 certificates Plans for masters of science in computer science













 Vice President for Student Affairs
Darlene Dilley
Associate VP of Enrollment Services
Dr. Peter Gitau
Vice President for Student Affairs
Darlene Dilley
Associate VP of Enrollment Services
Dr. Peter Gitau
Multicultural Inclusion Center


Daneka Souberbielle





Multicultural Inclusion Center








Dr. Catherine Odera

Director of International Student Affairs




Accommodating Growth

Meeting the Demand for Student Housing







Campus View Suites Open House











DSU Health & Counseling Center





Dr. Dylan Matsumori


Campus Master Plan

Current Campus


Campus Master Plan



15,000 students






Expanded Dining Services





Legend Solar Stadium





Legend Solar Stadium







DSU Athletics



4-time PacWest Community Engagement Award Winners
3-time Winner of the NCAA Community Engagement Award
Student athletes have an average of 3.08 GPA since 2013

Honoring Coach Allred




2015-2016 NCAA Regional Appearances






3rd Consecutive Year
8th Consecutive Year
5th Consecutive Year
8th Consecutive Year








•
Volleyball
Baseball •
•
Men’s Golf
•
Softball
PacWest Soccer Champions


Thank You!



































































































 Ryan Hobbs
Ryan Hobbs

Vice President for Student Affairs
Darlene Dilley
Associate VP of Enrollment Services
Dr. Peter Gitau
Vice President for Student Affairs
Darlene Dilley
Associate VP of Enrollment Services
Dr. Peter Gitau































































































